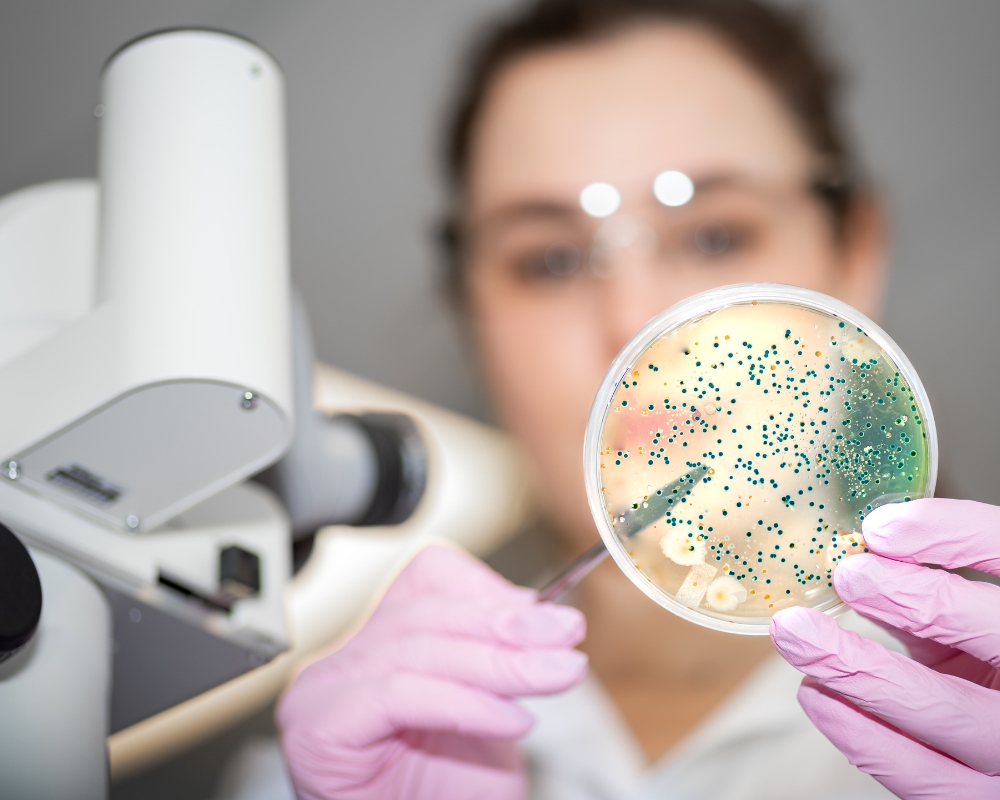

Công nghệ sản xuất mỹ phẩm sinh học
Bắt tay vào nghiên cứu & sản xuất mỹ phẩm sinh học từ những năm đầu thành lập, đến nay Geneworld đã có hơn 15 năm kinh nghiệm và trở thành đơn vị dẫn đầu ngành mỹ phẩm sinh học.
Các sản phẩm của Geneworld sử dụng thành phần an toàn, hàm lượng rõ ràng, được nghiên cứu tiền lâm sàng và lâm sàng bởi đội ngũ chuyên gia khoa học hàng đầu, trải qua quá trình kiểm định nghiêm ngặt để đạt chuẩn thế giới.
- Chiết xuất từ thành phần đạt chuẩn hữu cơ USDA-NOP an toàn cho da
- Thẩm thấu sâu, tác động đúng đích vùng da cần trị liệu nhờ ứng dụng công nghệ hiện đại
- Nói KHÔNG với các hợp chất hóa học gây kích ứng hoặc tác hại tiềm ẩn đối với da
- Cam kết phát triển bền vững từ việc trồng trọt, chăm sóc đến khai thác nguyên liệu…
Với chất lượng được kiểm nghiệm nghiêm ngặt cùng dây chuyền sản xuất đạt chuẩn GMP ASEAN, Geneworld đã tạo dựng được niềm tin với khách hàng, và được hơn 500+ Spa, thẩm mỹ viện, phòng khám da tin chọn.
Geneworld và đội ngũ các nhà nghiên cứu sẽ tiếp tục nghiên cứu, phát triển để mang tới những sản phẩm mới, chất lượng cao, phục vụ người tiêu dùng Việt.
Bài viết liên quan
BĂNG VẾT THƯƠNG DẠNG GEL TẾ BÀO GỐC - RADISKIN
Thông tin chung về sản phẩm: Radiskin là sản phẩm trang thiết bị y tế có thành phần chính là Tế bào gốc Nhung hươu, Tảo Spirulina giúp làm dịu da, giảm kích ứng và dưỡng ẩm hiệu quả, thí...
Công nghệ sản xuất mỹ phẩm sinh học
Bắt tay vào nghiên cứu & sản xuất mỹ phẩm sinh học từ những năm đầu thành lập, đến nay Geneworld đã có hơn 15 năm kinh nghiệm và trở thành đơn vị dẫn đầu ngành mỹ phẩm sinh học. Các sản phẩm củ...
Công nghệ Nano
Là một trong những công ty sở hữu đa dạng các công nghệ, công nghệ Nano được GENEWORLD ứng dụng trong nhiều dòng sản phẩm mỹ phẩm và thực phẩm bảo vệ sức khỏe. Công nghệ Nano sử dụng vật liệu ở qu...